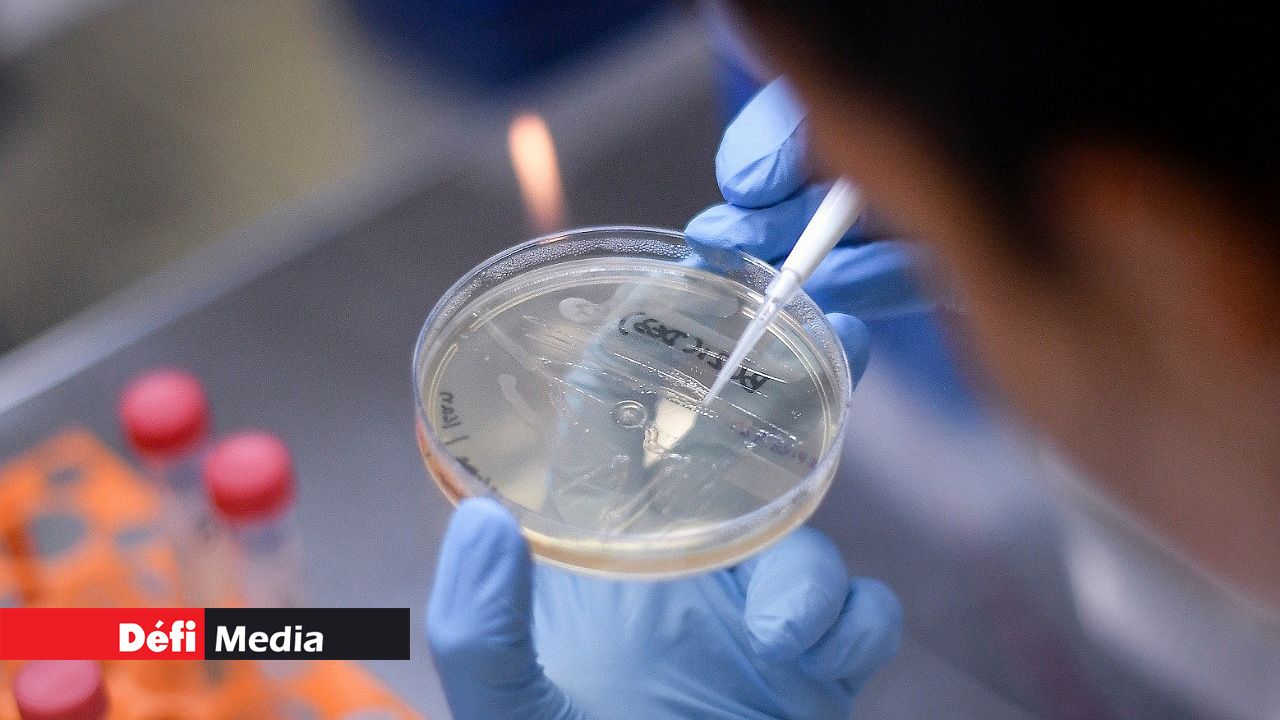

L'organisme gouvernemental britannique chargé de la cyber-sécurité a accusé jeudi un groupe de hackers de s'en prendre à des organisations britanniques, canadiennes et américaines pour voler leurs recherches dans la mise au point d'un vaccin contre le nouveau coronavirus, affirmant qu'il est "presque certain" qu'ils opèrent pour les renseignements russes.
"Le groupe menaçant connu sous le nom d'APT29" ou encore des "Ducs" ou de "Cozy Bear", "opère presque certainement dans le cadre des services de renseignement russes", a affirmé dans un communiqué le National Cyber Security Centre (NCSC), ajoutant que ses homologues américains et canadiens étaient arrivés à la même conclusion.
© Agence France-Presse

Notre service WhatsApp. Vous êtes témoins d`un événement d`actualité ou d`une scène insolite? Envoyez-nous vos photos ou vidéos sur le 5 259 82 00 !





















